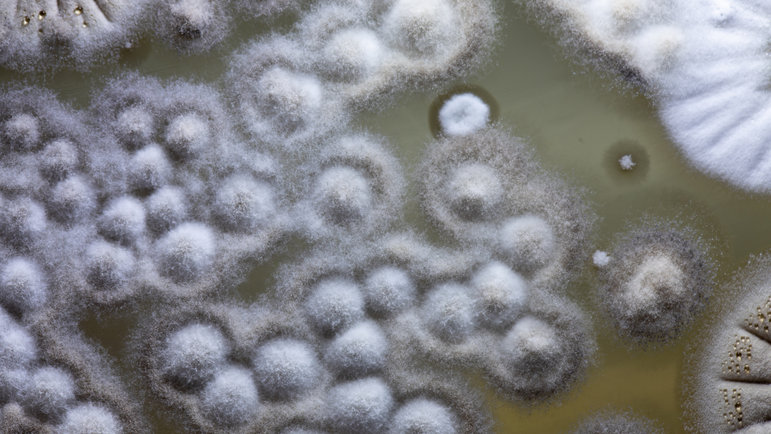
Dans le monde, 1,27 million de décès seraient liés à l’antibiorésistance.

Dans le monde, 1,27 million de décès seraient liés à l’antibiorésistance.Sinhyu / iStock / Getty Images Plus / via Getty Images
En 1928, l'observation fortuite d'Alexander Fleming marque un tournant décisif dans l'histoire de la médecine : la découverte de la pénicilline. Près d'un siècle plus tard, l'antibiorésistance progresse à un rythme préoccupant. Sans évolution favorable, les infections bactériennes pourraient redevenir en 2050 l'une des premières causes de mortalité mondiale, nous ramenant à l'ère préantibiotique.
Face à cette menace de santé publique, la lutte contre l'antibiorésistance mobilise l'ensemble des acteurs de santé.
Une découverte pas si fortuite
Le 3 septembre 1928 à Londres, Alexander Fleming, de retour de vacances, observe l’inhibition de cultures de staphylocoques par des colonies de Penicillium notatum ayant contaminé accidentellement ses boîtes de Petri. Ce phénomène le conduit à isoler un principe actif aux propriétés antibactériennes
Cette anecdote nourrit l’idée de la sérendipité de cette découverte. En réalité, elle s’inscrit dans un continuum de travaux menés du XIXe au début du XXe siècle sur les maladies infectieuses. À cette époque, Louis Pasteur et Jules Joubert avaient déjà mis en évidence la compétition entre micro-organismes sur un même substrat. Joseph Lister, en 1871, avait observé l’activité de champignons du genre Penicillium sur certaines bactéries. On dénombre à cette période une dizaine de publications faisant état de l’action des moisissures contre les bactéries.
C’est dans ce contexte que s’inscrivent les travaux d’Alexander Fleming, récompensés en 1945 par un prix Nobel partagé avec Howard Walter Florey et Ernst Boris Chain [1, 2].
La découverte de la pénicilline permit de maîtriser de nombreuses maladies infectieuses avec un impact majeur sur la démographie du XXe siècle. Les procédés techniques développés pour sa fabrication servirent de modèles au développement industriel de nombreux autres principes actifs comme certains anticancéreux et anticorps monoclonaux [3].
Lutter contre l’antibiorésistance : un défi mondial
La résistance aux antibiotiques se traduit par une perte d’efficacité thérapeutique sur les bactéries pathogènes ciblées, entraînant une pression de sélection favorisant l’apparition de bactéries résistantes [4]. Ces dernières vont pouvoir se développer, se disséminer et devenir progressivement prédominantes.
L’acquisition de résistance se fait par mutation génétique ou par transfert de plasmides entre individus d’une même souche ou entre espèces différentes. Ce mécanisme est le plus répandu, et à l’origine de l’émergence de souches multirésistantes.
D’après la synthèse réalisée par Santé publique France, on estimait, en 2019 :
- 1,27 million de décès liés à l’antibiorésistance dans le monde
- 865
- 103
- 4
Les projections indiquent que, si la situation n’évolue pas favorablement, les maladies infectieuses pourraient redevenir, en 2050, l’une des premières causes de mortalité dans le monde [5, 6].
L’antibiorésistance complexifie la prise en charge d’infections bactériennes, même bénignes. Elle augmente les durées de traitement, les risques de complications, les hospitalisations et la mortalité.
Plusieurs leviers sont employés pour lutter contre ce phénomène :
- une meilleure utilisation des antibiotiques : la bonne molécule pour la bonne indication, au bon dosage, pour la bonne durée de traitement
- l’adoption de mesures barrières pour lutter contre la transmission d’infections bactériennes
- le respect des normes d’hygiène alimentaire
- la vaccination [5].
Le rôle du pharmacien d’officine dans la lutte contre l’antibiorésistance
En tant que professionnels de santé de proximité, les pharmaciens disposent désormais de nouvelles missions s’inscrivant dans la lutte contre l’antibiorésistance.
La réalisation des tests rapides d’orientation diagnostique (TROD)
Depuis le 19 juin 2024, les pharmaciens d’officine peuvent délivrer, après réalisation d’un TROD, des antibiotiques dans la prise en charge :
- des angines bactériennes à streptocoque du groupe A chez les patients de plus de 10 ans présentant une odynophagie
- des cystites aiguës simples chez les patientes de 16 à 65 ans présentant une pollakiurie et des brûlures mictionnelles sans fièvre.
Ces protocoles permettent de contribuer directement à la rationalisation de l'usage des antibiotiques, en évitant les prescriptions inappropriées dans les infections virales et en assurant un traitement précoce des infections bactériennes avérées [7, 8, 9].
Selon les données du GIE GERS, groupement d’intérêt public, 72 % des officines proposaient le TROD angine en 2024, tandis que 58 % ont délivré le TROD cystite [10].
La vaccination à l’officine
La vaccination constitue un second levier d’action. Depuis le 8 août 2023, les pharmaciens d’officine peuvent prescrire et dispenser aux adultes, enfants et adolescents de plus de 11 ans l’ensemble des vaccins du calendrier vaccinal (à l’exclusion des vaccins vivants chez les patients immunodéprimés).
Promotion de la prévention
Enfin, le pharmacien rappelle au comptoir les conseils prophylactiques, comme les règles hygiéno-diététiques. En cas de prescription d’antibiotique, il dispense des conseils adaptés, optimise leur bon usage en veillant à l’observance et en alertant sur les possibles effets indésirables. La gestion des médicaments non utilisés (MNU) participe également à cette démarche.
La collecte des antibiotiques non utilisés prévient le mésusage ultérieur et l'automédication inappropriée, tout en sensibilisant les patients aux risques environnementaux [4].
[1] Roussel et al. Des moisissures à la pénicilline, quelques « prélèvements » dans la « colonie » des précurseurs. Histoire des Sciences médicales, 1981, 15 : 29-38
[2] Gaynes R. The Discovery of Penicillin - New Insights After More Than 75 Years of Clinical Use. Emerg Infect Dis., 2017 May; 23(5): 849–853
[3] Kardos N, Demain AL. Penicillin: the medicine with the greatest impact on therapeutic outcomes. Appl Microbiol Biotechnol., 2011 Nov; 92(4): 677-87
[4] Agathe Vernhet et al. Antibiorésistance, quels rôles pour le pharmacien d’officine ? Actualités Pharmaceutiques, 2026; 55, 556: 37-40
[5] Résistance aux antibiotiques : la problématique (Santé publique France, mis à jour le 20 janvier 2025)
[6] B. Coignard. Antibiorésistance : la situation en France et dans le monde. Bulletin de l'Académie nationale de médecine, 2019 ; 203 : 3-4 : 159-169
[7] Dépistage des cystites simples à l’officine (ameli.fr, 26 février 2025)
[8] Test rapide d’orientation diagnostique (TROD) angine à l’officine (ameli.fr, 6 juin 2025)
[9] Tests rapides d’orientation diagnostiques (TROD) (ameli.fr, 28 janvier 2025)
[10] Nouvelle année record pour l'officine (lesechos-etudes.fr, 22 janvier 2025)

 4 minutes
4 minutes Ajouter un commentaire
Ajouter un commentaire




Commentaires
Cliquez ici pour revenir à l'accueil.